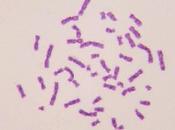
mejor autorretrato

Científico — Charles Darwin
Científico — Charles Darwin
-
Entre el 1 y el 4% del material genético del humano moderno procede de los...

Desde que Charles Darwin escribiera en 1859 El Origen de las Especies, los estudios sobre fósiles han configurado la historia de la vida sobre la Tierra. Y más... Leer el resto
El 20 junio 2012 por Carerac
NONE -
Realidades y ficciones

REALIDADES Y FICCIONES –Revista Literaria–Nº 1 – Agosto de 2010 – Año I Sumario: Literatura• La obra de arte, de Antón Chéjov. Cuento y análisis.• De cómo se... Leer el resto
El 04 junio 2012 por Hectorzabala
NONE, NONE -
¡Piratas!-Notas de producción

En ¡Piratas!, Hugh Grant protagoniza su primer personaje animado como el Capitán Pirata, de espesa y exuberante barba – un ... Leer el resto
El 31 mayo 2012 por Juancarbar
NONE, NONE -
¿Cuál es el nivel de interés social hacia la ciencia?

La Fundación BBVA ha hecho público este mes un Estudio Internacional de “Cultura Científica”. Aquí van algunas reflexiones sucitadas por este informe, en... Leer el resto
El 28 mayo 2012 por Icmat
NONE -
Qué es el Síndrome de Asperger?

Las personas con Síndrome de Asperger (AS) tienen inteligencia normal o, en ocasiones, superior a la media y la memoria suele estar muy desarrollada. Leer el resto
El 24 mayo 2012 por Luiscastellanos
NONE -
El nuevo emprendedor socialmente responsable

Estimad@s amig@s“La empresa es la única herramienta eficaz para vencer a la pobreza y el desempleo. Sólo la iniciativa privada crea prosperidad y desarrollo,... Leer el resto
El 08 mayo 2012 por Javier Pérez Caro
NONE, NONE, NONE, NONE -
¡Piratas! Una loca aventura

¡Piratas! Una loca aventura entretiene aún a los adultos forzados a mirar la versión doblada y por lo tanto sin posibilidad de reconocer las voces que Hugh... Leer el resto
El 02 mayo 2012 por María Bertoni
NONE -
De la transgresión a la impostura

“Confesad y seréis colgado” Christopher Marlowe, El judío de Malta Uno de los motivos básicos para convertirse en un impostor, es decir, para falsear la propia... Leer el resto
El 02 mayo 2012 por Peterpank
NONE, NONE -
Top 15 mensual. Lo más leído escrito desde el 01 abril 2012.

Por Manuel Gross Osses Pensamiento Imaginactivo Los 15 artículos más leídos, sobre management y otros temas relacionados, escritos po... Leer el resto
El 01 mayo 2012 por Manuelgross
NONE -
Lo que usted y yo desconocemos de las plantas carnívoras..... (el siguiente...

Ante el enigma de las plantas carnívorasCon unas mil 600 especies distribuidas en todo el orbe, en Cuba también existen Por Míriam Zito Este tipo de planta... Leer el resto
El 27 abril 2012 por Elambienteron
NONE, NONE, NONE -
Fisiología del asco

(…) Pero no más. El asco está teniendo su momento de gloria en tanto los científicos descubren que va mucho más allá de causar una sensación de malestar en el... Leer el resto
El 24 abril 2012 por Libretachatarra
NONE, NONE, NONE -
La asimilación de minerales en el Cámbrico pudo haber sido un factor clave para...

Hace más de 500 millones de años, durante una época conocida como la explosión del Cámbrico, nuevas categorías de formas de vida multicelulares aparecieron en u... Leer el resto
El 24 abril 2012 por Ame1314
NONE, NONE -
Gestione el cambio organizacional con los 6 niveles lógicos de pensamiento

Coaching: Liderar el cambio en las organizaciones con Robert Dilts Por Paz Garde Coaching para Jóvenes “Las especies que sobreviven no son... Leer el resto
El 05 abril 2012 por Manuelgross
NONE -
Leña al mono: La herencia del viento

Aquel que cree disturbios en su casa heredará el viento: y el tonto se convertirá en el sirviente del sabio de corazón. (Libro de Proverbios, cap. 11, ver. 29)... Leer el resto
El 28 marzo 2012 por 39escalones
NONE -
El bombín cuadrado - Evolución

Coordina La sombrerería Año 2012 Idioma Español Páginas 38 +info http://www.elbombincuadrado.com/ Descargar Millones de años después del evento más singular... Leer el resto
El 22 marzo 2012 por Javiercerezo
NONE -
Noticias Ciencia: Lunes, 5/3/2012
Anatomía El motivo de las distintas cantidades de grasa corporal en el gato, la rata y el murciélago Astronomía Apagones de radio en Australia, China e India po... Leer el resto
El 05 marzo 2012 por Cienciaaldia
NONE -
Grandes inventos y descubrimientos - Parte II

Si los ecos de tambores y señales de humo fueron las primeras manifestaciones de la comunicación a distancia, el telégrafo, la radio y el teléfono, son sus... Leer el resto
El 04 marzo 2012 por Cuarajy
-
Mi mejor autorretrato
Hace un par de días me encontré con esta foto que hice hace varios años, en ella aparecía una maraña desordenada de rayitas de color rosa. Esa imagen era mi... Leer el resto
El 26 febrero 2012 por Davidalvarez
NONE -
¿Descendemos de los monos?

Charles Robert Darwin nació en Londres el 12 de febrero de 1809 y se le recuerda como el padre de la teoría de la selección natural [todas las especies de... Leer el resto
El 12 febrero 2012 por Miguelangelgc
NONE, NONE, NONE -
La importancia de la taxonomía, un ejemplo

Enviado por Gonzonet a través de Google Reader: La importancia de la taxonomía, un ejemplo vía Biología y pensamiento de Emilio Cervantes el 31/01/12 Al leer... Leer el resto
El 06 febrero 2012 por Gonzonet
NONE -
Las luces y sombras de un genio

Para celebrar el bicentenario de Charles Dickens ya sabéis que he creado un reto en el blog para aquell@s que queremos (re)leer alguna obra de este autor. Si... Leer el resto
El 04 febrero 2012 por Carm9n
NONE, NONE -
La minoría elegida (los nuevos elegidos)

No es difícil rastrear hoy -y vayamos al grano-, en el discurso que emerge del mundo neoconservador norteamericano, el ascendiente de percepciones similares.... Leer el resto
El 30 enero 2012 por Gonzalo
NONE, NONE -
Estamos de acuerdo en que no estamos de acuerdo y que todo esto puede cambiar
"No es el más fuerte de las especies el que sobrevive, tampoco es el más inteligente el que sobrevive. Es aquel que es más adaptable al cambio" Charles... Leer el resto
El 28 enero 2012 por Rodrigofino
NONE, NONE -
La Flojera y la Influencia de la Alfalfa en el Siglo XXI

e imaginan que el Televisor que están viendo fuera antiguo como los de tubos?. ¿Se imaginan que a los ingenieros les hubiera dado flojera producir mejoras en... Leer el resto
El 20 enero 2012 por Blogmejorvendedor
NONE -
El origen de las especies y el lenguaje

El profesor Mark Pagel explica que los idiomas han seguido un desarrollo muy similar al de las especies tal como fue descrito por Charles Darwin. Leer el resto
El 20 enero 2012 por Alexborras
NONE, NONE -
Efemérides de la Mente – 27 de diciembre

Nace en 1915 William Howell Masters. Médico estadounidense que junto con su esposa investigó los aspectos físicos de la sexualidad y produjo uno de los más... Leer el resto
El 27 diciembre 2011 por Rgvecchio
NONE, NONE, NONE -
Darwin, sobre el “virus de la fe”
¿No serán, quizá, el resultado de una conexión entre causa y efecto, que, aunque nos da la impresión de ser necesaria, depende probablemente de una experiencia... Leer el resto
El 16 diciembre 2011 por Ceprio
NONE -
Día del Orgullo Primate: ¿qué se celebra?

En 1859, un veinticuatro de noviembre, se publicó El Origen de las Especies por Charles Darwin; casualidades del destino hicieron que en 1974, un 24 de... Leer el resto
El 06 diciembre 2011 por Miguelangelgc
NONE, NONE -
La falacia de los horóscopos y el Efecto Forer.

Por Emiliano Terán B. Razón Áurea. Una noche estrellada, con un cielo despejado, ejerce sobre nosotros una atracción tan... Leer el resto
El 25 noviembre 2011 por Manuelgross
NONE -
Feliz día del orgullo primate
Como nos recuerdan en el blog SinDioses: Hoy conmemoramos la publicación de "El Origen de las Especies" de Charles Darwin (1859), así como el descubrimiento de... Leer el resto
El 24 noviembre 2011 por Deimos
NONE -
¿Evolución?

La teoría de la evolución, formulada por Charles Darwin, sostiene que las especies evolucionan y cambian a lo largo de los siglos obligadas por la supervivencia. Leer el resto
El 22 noviembre 2011 por Dean
NONE -
National Geographic, manipulación mediática y prostitución intelectual por...

Querido Dr. Cesar guarde : Estimo mucho haber encontrado en la red social a cientificos que han despertado mi interès como futura maestra. opino , en mi... Leer el resto
El 21 noviembre 2011 por Georgeosdiazmontexano
-
La Royal Society cuelga en Internet los secretos de la revolución científica

La Royal Society, la institución científica más antigua del mundo, abre desde esta semana a consulta de los internautas su archivo histórico, miles de... Leer el resto
El 01 noviembre 2011 por Fat
NONE -
Antropología cultural moderna por josé de acosta

José de Acosta fue un antropólogo y jesuita que desempeñó importantes misiones en América a finales del siglo XVI efectuando análisis sobre hombres, animales,... Leer el resto
El 01 noviembre 2011 por Ilustrado
NONE, NONE, NONE -
La Royal Society libera su archivo histórico en Internet

Interesante noticia, sobre todo para aquellos que os guste la ciencia, puesto que la Royal Society, la institución científica más antigua del mundo, ha puesto... Leer el resto
El 31 octubre 2011 por Sarabiae
NONE -
Las raíces de la inteligencia de las plantas

Las plantas no tienen cerebro, las plantas no tienen ni una sola neurona… pero ahora sabemos que las plantas perciben lo que sucede a su alrededor, se... Leer el resto
El 28 octubre 2011 por Ktikaa
NONE, NONE -
Argumento: "Los humanos no somos animales porque no evolucionamos de ellos,...

En 1543, se publicó el libro De revolutionibus orbium coelestium (de las revoluciones de las esferas celestes) de Nicolás Copérnico (1473-1543). En él se... Leer el resto
El 19 octubre 2011 por Respuestasveganas
NONE, NONE, NONE, NONE -
Los argumentos geológicos y paleontológicos de los creacionistas "científicos":...
(Volver a "Los humanos no somos animales porque no evolucionamos de ellos, fuimos creados por Dios")A continuación publicamos un texto de Eustoquio Molina del... Leer el resto
El 19 octubre 2011 por Respuestasveganas
NONE, NONE, NONE, NONE -
El árbol de la vida. Por: Alfredo Abrisqueta

El árbol de la vida. Análisis y reflexiones.Hoy me gustaría hacer honor a una obra de arte, una obra maestra sin igual. Esta vez no se trata del arte... Leer el resto
El 17 octubre 2011 por Alfredo
-
Nacidos para aprender: el cerebro, de bebé a adolescente

En los últimos 25 años, la dimensión de los estudios por resonancia magnética han permitido a los científicos ver qué partes del cerebro se utilizan para... Leer el resto
El 09 octubre 2011 por Bebebibobu
-
¡Caracoles! ¿Qué haces tú aquí?

En un par de años se ha podido comprobar que Homo sapiens ha hibridado con otras especies de homínidos en su larga diáspora por el orbe terráqueo. Este... Leer el resto
El 30 septiembre 2011 por El Ojo De Darwin
NONE, NONE -
El origen de la especie humana
El origen de la especie humana¿Sabías que hasta hace apenas doscientos años casi todo el mundo creía que los seres humanos aparecieron en la Tierra tal y como... Leer el resto
El 27 septiembre 2011 por Alma2061
NONE -
Argumento: "Estamos hechos para comer carne porque tenemos caninos (colmillos)."

(Volver a "Los humanos somos omnívoros, por lo tanto, debemos comer carne")Algunas personas dicen que como los humanos tenemos colmillos (caninos) entonces... Leer el resto
El 27 septiembre 2011 por Respuestasveganas
NONE, NONE -
Argumento: "Los animales no piensan, no tienen inteligencia, no razonan"

(Volver a "Los animales no...")Algunos humanos dicen que los animales no-humanos no tienen pensamiento, o que si piensan entonces no son inteligentes ni... Leer el resto
El 25 septiembre 2011 por Respuestasveganas
-
Me Cago en la Biología
Interesante canción. Como la canción está plagada de vocabulario técnico os dejo aquí la letra con algunos enlaces que pueden ser esclarecedores. “Yo que lo... Leer el resto
El 20 septiembre 2011 por Cienciaaldia
NONE -
Frases de 'Paul'

Me encantaría verla. No, hoy no. Tres pechos. Genial. ¿Están de luna de miel? -¿Cree en aliens? -¿A qué se refiere con "aliens"? -¿“Observa el cielo” o... Leer el resto
El 20 septiembre 2011 por Libretachatarra
NONE -
Príncipe Carlos ayudará a construir un controversial albergue con 1.000 casas...
Traduccion:Jose Joaquin Loayza NavarretePríncipe Charles ayudará a construir un controversial albergue con 1.000 casas en las Islas Galápagos. Todos los... Leer el resto
El 15 septiembre 2011 por Ivan009
NONE, NONE -
Página temporal para la tienda

Autobiografía Charles Darwin Biblioteca Darwin Completa El creacionismo ¡vaya timo! Ernesto Carmena Los productos naturales ¡vaya timo! J.M. Mulet Las... Leer el resto
El 13 septiembre 2011 por Evolutionibus
-
Archipiélago Tierra del Fuego
Archipiélago Tierra del FuegoArchipiélago Tierra del Fuego, archipiélago situado en el extremo meridional de Sudamérica, de la que está separado al noroeste... Leer el resto
El 09 septiembre 2011 por Alma2061
-
Enciclopedia de la Vida (EOL)

Este es el mayor esfuerzo conjunto nunca realizado, para tener todas las especies juntas en un mismo sitio, la Enciclopedia de la Vida (Encyclopedia of Life, po... Leer el resto
El 06 septiembre 2011 por Blogdemambo
NONE -
Es un mundo pequeño, después de todo

Crédito: NASA MODIS (Wikipedia) Artículo publicado por Alan Buis y Whitney Clavin el 16 de agosto de 2011 en la web de JPL Un equipo de investigación dirigido... Leer el resto
El 05 septiembre 2011 por Jordiguzman
-
Tráiler y teaser pósters de '¡Piratas!'

Sony Pictures Releasing de España nos facilita el tráiler y teaser pósters de ¡Piratas!, que se estrenará en cines de toda España en Primavera de 2012, en 2D... Leer el resto
El 03 septiembre 2011 por Davicine
NONE -
¿Qué es la ilustración?

El autor de está obra no necesita presentación, Immanuel Kant, uno de los filósofos más grandes e importantes de todos los tiempos. Hacía tiempo que andaba... Leer el resto
El 29 agosto 2011 por Deimos
NONE -
Lagartos, iguanas, tortugas y la evolución abofeteandote la cara

Este artículo se publica simultáneamente en Amazings.es Noventa grados oeste, treinta minutos sur, coordenadas simples, pero más allá de los impersonales... Leer el resto
El 10 agosto 2011 por Deimos
NONE -
El Carnaval de la Evolución

es una de las variedades de la iniciativa Blog Carnival. Cualquiera puede hacer un carnaval: se trata de recopilar artículos que “donen” diferentes autores sobr... Leer el resto
El 04 agosto 2011 por Evolutionibus
-
Velorios Creativos: Reflejos del Nuevo Morbo Boricua
Resulta difícil entender por qué hay ritos; pero podemos afirmar que los hay para todo — para casarse, para congraciarnos con la muchedumbre religiosa, para... Leer el resto
El 28 julio 2011 por Adrover
NONE, NONE -
Nacidas de los infiernos

Recientemente he tenido la fantástica oportunidad de visitar las islas Galápagos. La fama de estas islas en buena parte se debe a que influyeron en el trabajo d... Leer el resto
El 26 julio 2011 por Deimos
NONE -
Animales con sentimientos (Jesus Mosterín, diciembre 2000)
(Volver a "Los animales no tienen emociones ni sentimientos")Jesus Mosterín es catedrático de lógica y filosofía de la ciencia en la Universidad de Barcelona y... Leer el resto
El 22 julio 2011 por Respuestasveganas
NONE, NONE, NONE, NONE -
Argumento: 'Los animales no tienen emociones ni sentimientos'

(Volver a "Los animales no...")Algunas personas dicen que los animales no-humanos no tienen emociones ni sentimientos y que ello justifica que los podamos ... Leer el resto
El 22 julio 2011 por Respuestasveganas
NONE, NONE, NONE, NONE -
'La evolución de Calpurnia Tate', de Jacqueline Kelly

Por fin ha llegado el día que subo esta reseña. Ha costado (el querer hacerla perfecta y la guerra que me está dando la no-muela no ayuda) pero aquí está. Al... Leer el resto
El 21 julio 2011 por Cris
NONE, NONE -
Grandes hombres vemos… perversiones no sabemos

Bienvenidos al Sitio Web www.informanet1.com Director General: Erasmo Martínez Cano… Comentarios y sugerencias: Editor: Erasmo Martínez / Javier Tlatoa (... Leer el resto
El 14 julio 2011 por Erasmo
-
Hacia los confines del mundo

Estamos ante una novela historia, cuyo tema principal es uno de los viajes de descubrimiento más importantes que probablemente se ha realizado en la historia... Leer el resto
El 07 julio 2011 por Deimos
NONE -
HOWARD GARDNER: Los nuevos paradigmas de Mentalidad
Howard Gardner (66) Es uno de los psicólogos más importantes de Estados Unidos. Su día transcurre entre clases, charlas, viajes y reuniones en la Universidad... Leer el resto
El 03 julio 2011 por Srigangamata
NONE -
La biblioteca de Darwin al alcance de tu ratón

Darwin fue un ávido lector, es de sobra conocido que obras como los Principios de Geología de Charles Lyell o Ensayo sobre el principio de la población de Thoma... Leer el resto
El 23 junio 2011 por Deimos
NONE, NONE -
100 libros sobre el ateísmo y todo lo demás

En total más de 150 libros, artículos, conferencias, cartas, poemas, esculturas, canciones, películas y documentales sobre la religión, el conocimiento, la... Leer el resto
El 06 junio 2011 por Hugo
NONE, NONE, NONE -
La Planta Telégrafo

Teníamos ya la planta bloguera y claro, nos faltaba la telégrafo. Sí, nuestras plantas son muy inteligentes. Ahora, la verdad es que no sabemos si podríamos... Leer el resto
El 02 junio 2011 por Plantamer
NONE, NONE, NONE, NONE -
Se ha ido un amigo: Charles Porset, un Referente del RF

Hace apenas unas horas que un buen amigo, un hombro de confidencias, un Maestro y un volteriano Hermano ha pasado al Oriente Eterno, se fue sin despedirse, o... Leer el resto
El 26 mayo 2011 por Vguerra
NONE, NONE -
Migrañas
La migraña, también llamada hemicránea y jaqueca, además de ser un castigo bíblico por algún horrible acto cometido en alguna anterior vida, es un tipo de... Leer el resto
El 23 mayo 2011 por Gasolinero
NONE, NONE -
Noticias científicas de la semana

Noticias científicas A partir de hoy, cada domingo haré un listado de las noticias científicas más interesantes de la semana (en mi opinión claro), traidas a... Leer el resto
El 16 mayo 2011 por Drgen
NONE -
Concepto de evolución
El Diccionario de la evolución, de Richard Milner, es un compendio sobre el evolucionismo desde sus orígenes hasta la actualidad. Leer el resto
El 06 mayo 2011 por Alma2061
-
Creation

Creation es la película que los creacionistas norteamericanos lograron boicotear. Tras haberle perdido la pista desde 2009, logré echarle el guante por el... Leer el resto
El 02 mayo 2011 por Evolutionibus
-
Grandes momentos tv (XIX)
Monólogo de Nathan Young en el último capítulo de la primera temporada de Misfits (sin spoilers). Os ha hecho creer que así es cómo debéis ser. ¡Pero no es... Leer el resto
El 30 abril 2011 por Quesito
NONE, NONE -
Descripción de varios de los personajes de X-Men: Primera Generación

Los chicos de MSN han tenido la oportunidad de sentarse con la mayoría de los componentes del reparto de X-Men: Primera Generación y cada miembro ha hablado un... Leer el resto
El 28 abril 2011 por The Leff
NONE, NONE -
Lección de Geografía para estadounidenses

Daniel Estulin.- Según una de las últimas encuestas del USA Today, los estadounidenses son tan malos en geografía como en historia mundial. Por ejemplo, 78%... Leer el resto
El 22 abril 2011 por Norelys
NONE -
Los 100 libros.

Seguro que entre los 129.864.880 ejemplares de libros que esta digitalizando Google Books (y que es la cifra “oficial” del número de libros que hay en el... Leer el resto
El 22 abril 2011 por Bypils
-
Plantas con flores: Teoría evolutiva

Hojas El hallazgo de un fósil en el noreste de China podría explicar la contradicción entre el origen de las plantas que tienen floración y la teoría... Leer el resto
El 19 abril 2011 por Plantamer
NONE, NONE -
Las élites de Aguirre
La noticia reciente de la señora Aguirre, sobre la segregación de la “créme de la créme” de las aulas madrileñas en centros de élite intelectual desprovistos d... Leer el resto
El 11 abril 2011 por Abel Ros
NONE -
Discurshow: A divertirse con la ciencia
Si crees que la ciencia no puede ser divertida te invito a que te pases el próximo día 12 de abril a las 19:30, por el IrishCorner (el mismo pub donde se... Leer el resto
El 05 abril 2011 por Deimos
NONE -
El salón de los famosos

Decía mi santa abuela que cuando el diablo se aburre mata moscas con el rabo. No tengo claro que sea fruto del aburrimiento, pero el caso es que un grupo de... Leer el resto
El 26 marzo 2011 por Jal
NONE -
Academia Inquietorum (IV): Sonrie, Duchenne.

Hoy quiero relatar la historia de un desafortunado e introvertido, pero genial, médico: Guillaume Benjamin Amand Duchenne, conocido como Duchenne de Boulogne... Leer el resto
El 21 marzo 2011 por Matilido
NONE, NONE -
Los reinos de la vida
Enviado por Ana Candelaria Ortega DugartePartes: 1, 2, 3, 4, 5, 6, 7Introducción Historia Sistema de los cinco reinos Sistema de los tres dominios Resumen... Leer el resto
El 17 marzo 2011 por Gonzonet
NONE, NONE -
Que no te corten las alas

Al inicio de una conferencia sobre stress, el disertante colgó frente al público una gran hoja de papel blanco. Con un marcador negro dibujó luego una... Leer el resto
El 05 marzo 2011 por Juan Carlos Valda
NONE, NONE -
Paul Erdös entre los Santos Danzantes

Encontrarse con una imagen del matemático húngaro Paul Erdös en una procesión de santos bailando parece improbable, pero puede ocurrir en St. Gregory of Nissa,... Leer el resto
El 16 febrero 2011 por Eliatron
NONE -
Las matemáticas de Darwin

El último número de la revista ARBOR (Vol 186, No 746 (2010) doi:10.3989/arbor.2010.i746) está dedicada a resaltar algunos de los aspectos matemáticos de la... Leer el resto
El 16 febrero 2011 por Icmat
NONE -
¡Feliz Día de Darwin!

Este 12 de febrero se cumplirían 202 años del nacimiento del naturalista Charles Darwin, también conocido como el padre de la evolución. Desde hace algunos... Leer el resto
El 12 febrero 2011 por Ezeqdb
NONE, NONE -
Darwin Vs los testigos de Jehová

Hoy 12 de febrero se conmemoran 200 años del natalicio de Charles Darwin, el hombre que nos mostró la revolucionaria idea sobre nuestro origen: la teoría de la... Leer el resto
El 12 febrero 2011 por Ivanpok
-
Teoría del involucionismo

Según Darwin, en el origen de las especies, «El resultado final es que todo ser tiende a perfeccionarse cada vez más en relación a sus condiciones. Este... Leer el resto
El 05 febrero 2011 por Anveger
-
Imágenes de Evolución (II)

Acá les traigo otra tanda de imágenes de evolución. Imágenes de Evolución alternativas (II) Evolución del Helado: Esta primera me tomó por sorpresa, pedí un... Leer el resto
El 21 enero 2011 por Drgen
NONE, NONE -
Despidiendo el 2010
Llevo más de un año con esta frase guardada, esperando que fuera el último post, despidiéndome del blog. Hasta el momento no he decidido dejar de escribirlo (co... Leer el resto
El 31 diciembre 2010 por Fersinski
NONE -
Cuanto más se sabe acerca de las leyes fijas de la naturaleza más increíbles...

«Reflexionando sobre la necesidad de disponer de evidencias claras como requisito para que cualquier hombre en su sano juicio creyera en los milagros sobre los... Leer el resto
El 20 diciembre 2010 por Bayo
NONE, NONE -
Parásitos en la naturaleza: Evidencia de la evolución

En la naturaleza existen muchas relaciones entre especies. Algunas más complejas que otras, pero todas ellas complejamente generadas por el proceso evolutivo.... Leer el resto
El 11 diciembre 2010 por Daniel_barona1981
NONE, NONE -
Silicona en el Ex-Corazón

“No puedes depender de tus ojos cuando tu imaginación está fuera de foco”. (Charles Darwin)No es lo que percibes, sino lo que es. Así que... Leer el resto
El 11 diciembre 2010 por Sextohombredigital
NONE -
Día del orgullo primate

Desde Homínidos nos unimos a la celebración del Día del Orgullo Primate, una iniciativa del portal Sin Dioses.¿Qué tiene de especial el 24 de Noviembre para... Leer el resto
El 24 noviembre 2010 por Deimos
NONE -
El curioso y cambiante temperamento del mercado
Nunca esta de más recordar este video, para enfrentar con algo de humor lo que viene, a proposito del mal ánimo del mercado Diversas expresiones dan cuenta d... Leer el resto
El 17 noviembre 2010 por Jaque Al Neoliberalismo
NONE, NONE -
El conocimiento científico versus las supersticiones del "sentido común"

¿Qué tiene que ver la Ciencia con el sentido común? Por Antonio Martínez Ron Muchos escépticos, especialmente en Estados... Leer el resto
El 12 noviembre 2010 por Manuelgross
NONE -
América - Egipto SER Historia

De la mano de Miguel Rivera Dorado, profesor de Cultura Maya en la Universida Complutense de Madrid, nos adentramos en los misterios de las relaciones que pudo... Leer el resto
El 06 noviembre 2010 por Wloghero
-
El Efecto Dunning-Kruger: Los que se creen mejores que el promedio

El Homo Arrogantis Por Myriam López Blanco El mundo está gobernado por una especie de primates bípedos que se han bautizado a sí... Leer el resto
El 31 octubre 2010 por Manuelgross
NONE -
Democracia y desórdenes mentales

Este artículo de David Brooks publicado en La Jornada, nos da cuenta del circo en que se ha convertido el mundo actual, donde el payaso mayor es Sarah Palin,... Leer el resto
El 19 octubre 2010 por Jaque Al Neoliberalismo
NONE, NONE -
¿Qué hacer cuando un Proyecto fracasa?

solicitud de una de mis lectoras es que escribo de este tema. No hay duda de que es un punto sensible en todo proyecto o emprendimiento. Leer el resto
El 19 octubre 2010 por Blogmejorvendedor
NONE -
René quinton: un sabio en el olvido

Descubrió el agua del mar como elemento indispensable para la vida y la salud. René Quinton nació el 15 de diciembre de 1866 en Chaumes, Brie (Francia). Leer el resto
El 14 octubre 2010 por Pedro Pozas Terrados
NONE